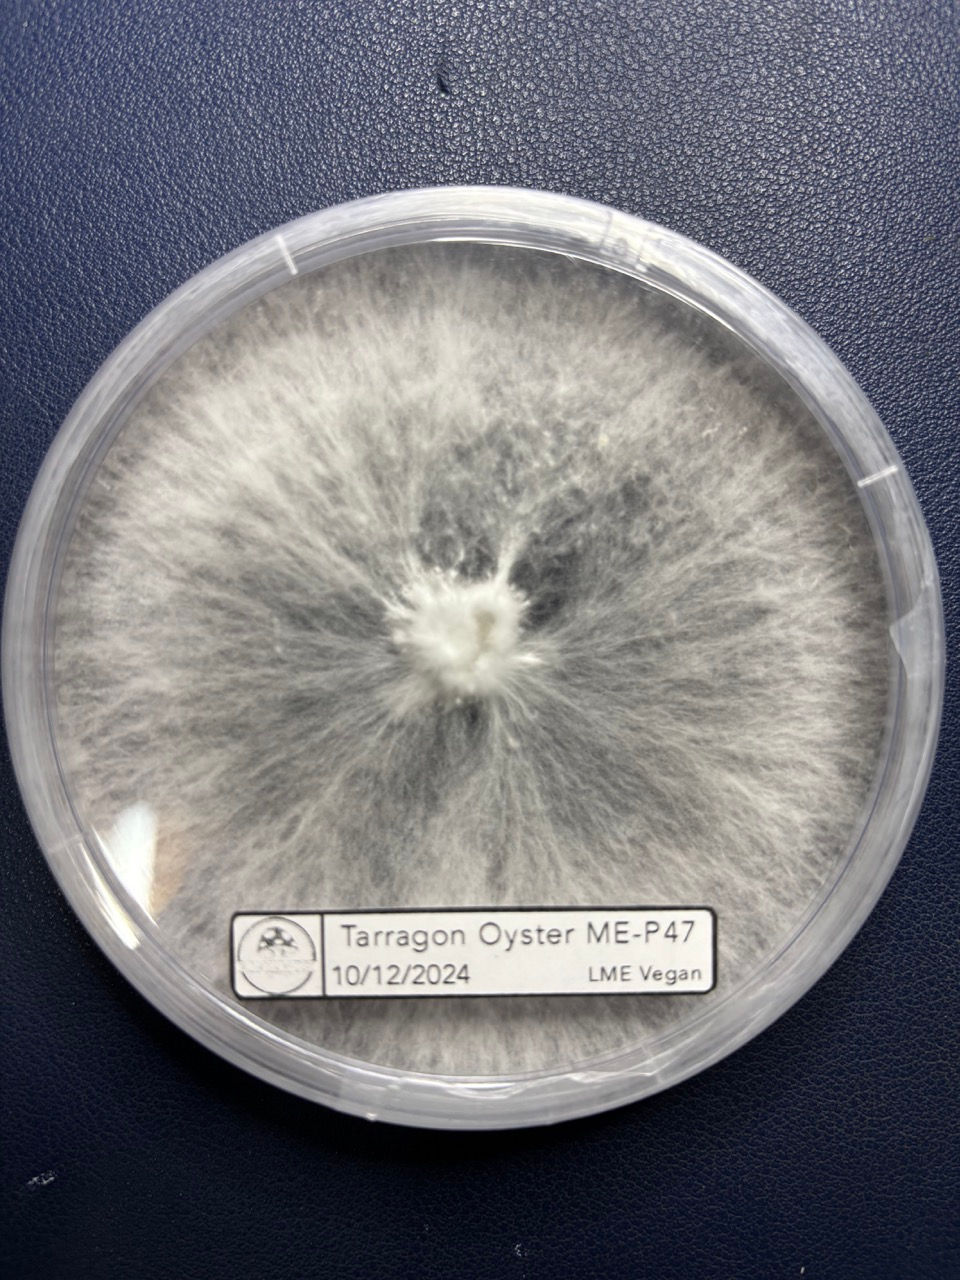

top of page

למגדלים
בין אם אתם רק נכנסים לתחום, או מנוסים מאוד, אי אפשר בלי ציוד מתאים!
כאן, בחוות MushroomMasters אנחנו שמחים להציע לכם את הגנטיקה שלנו. תוכלו להזמין גנטיקה מסחרית, שיעילותה הוכחה, ושאנחנו מתחייבים כי נשמרה בתנאים הקפדניים ביותר - עד לרגע בו הגיעה אליכם!
אפשר להזמין את הגנטיקה במגוון צורות: צלחות פטרי, מזרקים, נוזלים בצנצנות, מזרעי חיטה וגם ערכות להפרחה קטנות וגדולות.
בכל שאלה, אנחנו כאן לעזור
bottom of page